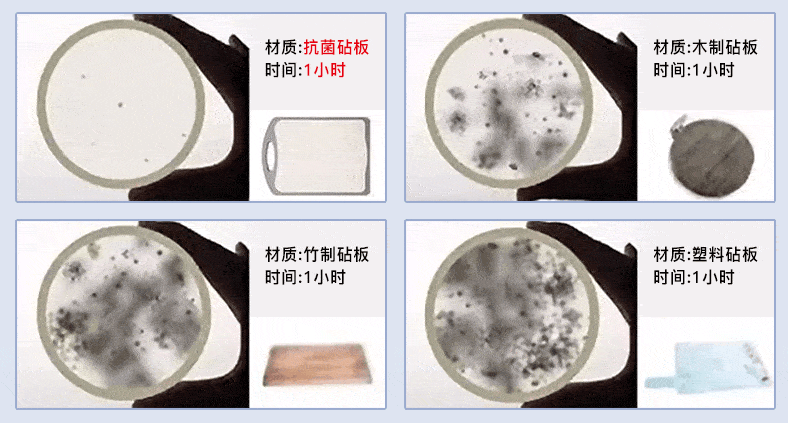

想丢吧,还能用舍不得
继续用吧,又不敢冒这个险
有节目报道过:1㎡的菜板,细jun、寄生虫是马桶的200倍!

更别说,上面很可能隐藏着让人闻风丧胆的—级致ai物:黄曲mei菌。
它的毒性,是pi霜的68倍!仅1毫克,就会损伤肝脏功能,诱发 肝ai、骨ai等等,是杀人不眨眼的“凶手”。

它经得住冲洗,也承受得了高温,就算用油炸,也弄不死它。

每天在这样的砧板切菜,都无形中裹满了细 '菌、寄 '生 '虫、致ai物 ,再进入你的口中。
引起腹泻、呕吐、中毒,免 '疫 '力低的 小孩和老人更容易中招。
之前就报道过:
有人患上了肝ai去世
她家的是砧板黄曲霉jun超标了!

看到这里,你是不是已经想把家里那块用了很久、带着经年累月细 '菌的砧板换掉了?
在后台也有很多粉丝留言要求:找一个好用不发霉的砧板。
我也一直在为这事儿上心。
试用过木砧板、不锈钢砧板、塑料菜板,但多多少少都有槽点:

老爸测评的几款竹菜板,竟然都是烂木头、边角料用大量胶水拼凑而成的“黑心菜板”

并且送去实验室检测,几乎都检测出了甲 '醛 。
这样的菜板,你真的放心用嘛?

所以,当有厂家把他家的竹菜板寄过来时,我内心是拒绝的,但确实又被它的颜值打动了。
长这样▽是不是挺好看?

于是带回家让我妈试试看,用了大半年利用率竟然很高。
据我妈说“手感很厚实,不会轻飘飘的,切菜很有手感,用到现在还没开裂、发霉。
生熟分切,一面切肉剁骨头、一面切菜切水果,不会串味。”

可能是有了这个使用基础吧,所以当厂家第2次找我推荐这块、他引以为傲的菜板时,我才放下“偏见”好好了解它。

原来这个竹菜板,不是什么边角料拼接而成,而就是一整片玩美的竹子,通过物理操作把竹子切开压平。

你们看,它表面跟拼接的竹菜板真的不一样。
低头闻还有清新的竹香。

而且竹子本身就有防水、抑jun、硬度高的优 '良特性, 用它做出来的菜板:
不易渗水✔
不易发霉✔
不易起屑✔
更何况它还是高山楠竹
(这点下面会仔细讲)

这种天 '然纯粹的保障,才是我们消费者zui在意的。
0胶水、0甲醛残留、无漆无蜡,无重金属,做菜更放心。

还有很吸引人的一点就是:
它另外一面是近几年很流行的麦谷物纤维,相比没有击菌效果的菜板,它已经获得检测报告:抑jun率高。
可以专门用来切菜、切水果、给宝宝做辅食。

这次上架前,我也小范围内测了一波,得到了大量好评。

所以今天正式给大家上架。
它是有两个规格的,小号(适合单身、三口之家)、大号(大家庭)。
现货不多各100件,抢完就没了
大家买回去试试看吧!
为什么菜板会发霉?
因为会渗水、吸汁,而且用久了会有刀痕,肉渣全藏里面了能不发霉吗?(对!我说的就是木菜板和塑料菜板)

但抛开那些“用胶水把边角料拼接起来的竹菜板 ”,竹子确实是天生做菜板的好材料。
优 '异的“拒水性”
不吸水不渗水,从根源杜绝发霉
“韧性好、硬度高”
不留刀痕不掉屑,耐用不易开裂
天 '然的防虫防 '菌
对 '抗细 '菌,做饭更安心

像这块菜板,更是采用了毛竹中价值zui高的高山楠竹。
不仅“肉厚”、而且密度、韧性、拒水性都远超其他竹子,很多大酒楼的老厨师、寿司店都会用楠竹菜板。

每一块原竹都需要经过高温软 '化、展平、干燥、打磨 等20多项繁琐工艺,而且因为每颗竹子的纹理不同,做出来的砧板也是独—无 '二的。

为了验证它,厂家给我们看了一组“简单粗暴”的产品测试:
把它和木菜板、其他品牌的竹菜板,同时放在水池旁。
一个星期后,其他两个菜板都有不同程度的发霉,只有它看起来还跟新的一样。

淋酱油上去,酱油直接“溜走”了,用水一冲干净。

因为不咬刀,刀起刀落的每一下都切得实实在在,就算是剁骨头都游刃有余,稳稳当当的。

拍蒜也不会弹起来,做饭事半功倍!

既保护了菜刀,也没有起屑、刀痕,更加不会藏污纳垢,大大延长了砧板的使用寿命。

看完我还是有点不放心,特意寄出去几件样品让朋友们做测试,给出的反馈都很不错!

这一面是专门切水果、蔬菜的,切完水果可以直接吃,因此对除 '菌要求要更高。

采用具有天 '然抗 '菌因子的麦谷纤维 ,zui大程度击菌。

厂家还找实验室做过了测试,把肉片放在砧板上,1小时后发现其他砧板滋生了大量细 '菌,而它只有零星的细 '菌。
并出具了实实在在的抗 '菌报告:对大肠杆 '菌等砧板常见有害菌, 抑zhi和杀mian率高。

除了切实存在的报告,麦谷纤维还具有不被虫蛀和微生物腐蚀的属性,通过高密度压缩,不留缝隙。

像我同事在厂家寄过来的第—时间,就把它“顺”回家用了。
她说住的地方比较潮湿,以前用超 '市买的菜板,不出一个月就发霉了,但这块已经接近半年, 还跟新的一样不发霉不发臭!

买回去做辅食,不用担心滋生细 '菌和起屑。

我妈包饺子也很爱用这一面,不粘菜板,清洗也很快。

细心的小伙伴一定观察到了。
这块砧板四周都有凹槽,切菜的时候可以“引流”,汁水不会流到案板。

厚度2cm左右,比超 '市那些轻飘飘的菜板厚实多了, 拿在手上很有分量,切起菜来不弹、不滑。

日常保养也很简单,水冲一冲挂起来自然晾干就可以了。

厂家告诉我,厂里都是三十多年经验的老 '师 '傅, 这个菜板花费心血比较大,很多线上线下的商 '铺都来订货。
疫 '情 '爆 '发的时候,就是靠这个砧板养活了工厂。

我也特意上网查了一下,单单这个整竹的工艺,叫得出名字的品牌价 '格都卖得很贵。

但这款整竹+麦谷纤维,双面设计,打折后才69元起,价 '格真的很良心了。
在功能上,切、砍、剁、拍它都经得起✔
在耐用度,不开裂、不变形、不伤刀,一块用好几年✔
在保养上,一点都不麻烦,冲一冲晾干就搞定✔
在安 '全角度,抗jun,不易发霉、不藏污纳垢,生熟分切✔
为了我们的健康有金 '钟 '罩保护,大家完全不需要吝啬这几十块钱。
心动的赶快下单啦!这个价 '格只有100件,卖完就没有了,买回去不喜欢,反正还可以退回来。
更多好物推荐
点击 阅读原文,亦可购买 返回搜狐,查看更多
